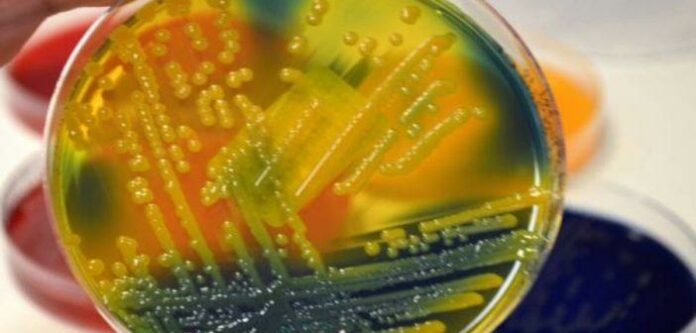

Дослідники розробили нанотехнологію на основі чорного фосфору, яка може вбити більше 99% стійких до ліків бактерій. Цей інноваційний матеріал, який розкладається при контакті з активними формами кисню, що виробляють кисень і вбивають бактерії, може бути використаний в ранових пов’язках, імплантатах і медичних інструментах для лікування і профілактики бактеріальних інфекцій.

Нове дослідження, проведене Університетом RMIT і Університетом Південної Австралії (UniSA), перевірило нанотехнології на основі чорного фосфору в якості передового засобу для лікування інфекцій і загоєння ран.
Результати, опубліковані в Advanced Therapeutics, показують, що він ефективно лікує інфекції, вбиваючи більше 99% бактерій, не пошкоджуючи інші клітини в біологічних моделях. Лікування досягло результатів, порівнянних з антибіотиком, в усуненні інфекції і прискоренні загоєння: рани закрилися на 80% за сім днів.
Нанотехнології для знищення супербактерій, розроблена міжнародною компанією RMIT, була ретельно протестована в ході доклінічних випробувань експертами по загоєнню ран UniSA. RMIT домігся патентного захисту пластівців чорного фосфору, включаючи його використання в складах для загоєння ран, включаючи гелі.
З-ведучий дослідник RMIT, професор Сумит Валія, сказала, що дослідження показало, як їх інновація забезпечує швидке протимікробну дію, а потім саморозкладається після усунення загрози зараження.
“ Унікальність нашої розробки полягає в тому, що це не просто покриття – воно дійсно може бути інтегровано в звичайні матеріали, з яких виготовляються пристрої, а також в пластик і гелі, щоб зробити їх протимікробними ”, — сказала Валія з інженерної школи RMIT.
Попереднє дослідження, проведене RMIT, показало, що чорний фосфор ефективний для знищення мікробів, коли наноситься нанотонкімі шарами на поверхні, що використовуються для виготовлення пов’язок на рани і імплантатів, таких як бавовна і титан, або вбудовується в пластмаси, які використовуються в медичних інструментах.